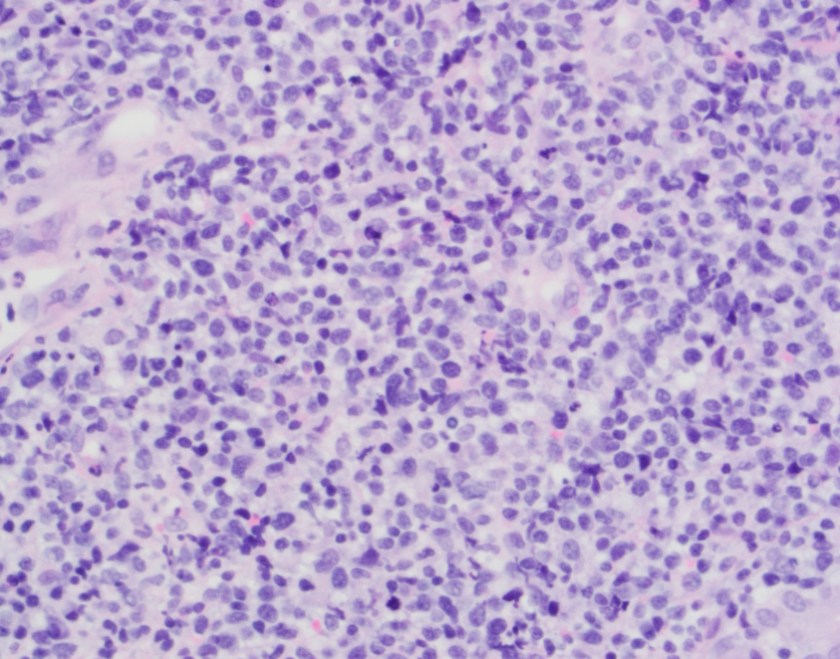
nkt-he40x

Case History
43 year old Vietnamese speaking man with a history of treated latent TB who presented with one month of fevers, night sweats, weight loss, and acute left facial swelling with associated pain, nasal congestion and 2 nose bleeds. The patient was found to have a polypoid mass within the left interior nasal cavity.
Biopsy Left Nasal Mass

Diagnosis
The biopsy shows nasal mucosa with a dense submucosal lymphoid infiltrate and large areas of necrosis. The lymphocytes are somewhat pleomorphic, medium to large in size with irregular nuclear contours, vesicular chromatin and inconspicuous nucleoli. There are scattered mitoses and apoptotic cells.
By immunohistochemistry, CD3 highlights the lymphoma cells, which comprise the majority of the lymphoid infiltrate. The lymphoma cells co-express CD56 and CD7 (dim) and are negative for CD2 and CD5. The lymphoma cells also express cytotoxic markers perforin and granzyme (major subset). CD20 highlights only rare small clusters of B-cells. The lymphoma cells are also positive for EBER (Epstein-Barr Virus encoded RNA) in situ hybridization. The Ki67 (MIB1) proliferation index is 60% with focal areas exhibiting up to 80%.
Taken together, the morphologic and immunophenotypic findings are consistent with an extranodal NK/T cell lymphoma, nasal type.
Discussion
Extranodal NK/T cell lymphoma, nasal type is an aggressive lymphoma that is more prevalent in Asian and South American populations. It occurs most often in adults and is more common in men than women. It is generally located in the upper aerodigstive tract, with the nasal cavity being the prototypical site. Patients tend to present in a manner similar to the patient described in this case, with rhinorrhea, pain, nasal obstruction and epistaxis due to a mass lesion. 1 The term “lethal midline granuloma” was once used to describe this entity because patients can present with locally destructive mid-facial necrotizing lesions. The early non-specific symptoms can pose a diagnostic challenge, and often result in treatment delays, which makes the aggressive disease more lethal. 2
The entity is described as NK/T cell lymphoma because although most cases are of NK-cell origin, some cases are comprised of cytotoxic T-cells. Natural killer (NK) cells are non-T and non-B lymphocytes that are part of the innate immune system. They respond immediately to antigenic challenge and are able to directly kill virally infected cells without the help of antigen presenting cells. They also secrete cytokines to increase the innate immune response. NK cells are classically positive for cytoplasmic CD3 and CD56, as well as cytotoxic molecules granzyme and perforin. Of note, NK-cells lack recombination activating gene enzymes and therefore have no clonal molecular marker for gene rearrangement such as the T-cell receptor or Immunoglobulin heavy chain. 3
Microscopically, the involved sites generally have widespread mucosal destruction. There is an angioentric and angiodestructive growth pattern that results in extensive necrosis. Another important diagnostic consideration is the very strong association with EBV. EBV is present in a clonal episomal form. This means that the infection occurs prior to and likely plays a pathogenic role in the development of NK/T cell lymphomas. 3
Following diagnosis, staging and management of the disease involves quantification of circulating EBV DNA. This can be used as a laboratory marker for disease status and progression or remission of disease. PET/CT is performed for accurate staging and patients are most commonly treated with a combination of radiotherapy and the SMILE regimen, which includes dexamethasone, methotrexate, ifosfamide, L-asparaginase and etoposide. NK/T cell lymphomas are aggressive and patients tend to have a short survival and poor overall response to therapy. 3
A recent study by Kwong, et al. showed the potential use of PD1 (programmed death ligand 1) blockade drug pembrolizumab in the treatment of relapsed or refractory NK/T-cell lymphoma. As mentioned above, the lymphocytes in this entity are invariably infected with EBV. PD1 is known to be up regulated in cells infected with EBV. In the study, seven patients who had failed treatment with the SMILE regimen were treated with pembrolizumab. After a medium follow-up of 5 months, 5 patients remained in complete remission and all patients had objective responses to treatment. 4 This shows promise as a potential new treatment for patients with this uncommon, but deadly disease.
References
- Swerdlow SH, Campo E, Harris NL, et al. WHO Classification of Tumours of Haematopoetic and Lymphoid Tissues (Revised 4th edition). IARC: Lyon 2017.
- Mallya V, Singh A, Pahwa M. Lethal midline granuloma. Indian Dermatology Online Journal. 2013;4(1):37-39. doi:10.4103/2229-5178.105469.
- Tse, E, Kwong, Yok-Lam. The diagnosis and management of NK/T-cell lymphomas. Journal of Hematology and Oncology. 2017:10:85. Doi: 10.1186/s13045-017-0452-9.
- Yok-Lam, K, Thomas, S.Y. Chan, Daryl Tan, et. al. PD1 blockade with pembrolizumab is highly effective in relapsed or refractory NK/T-cell lymphoma failing L-asparaignase. Blood. 2017:129:2437-2422. Doi: 10/1182/blood-2016-12-758641.

–Chelsea Marcus, MD is a third year resident in anatomic and clinical pathology at Beth Israel Deaconess Medical Center in Boston, MA and will be starting her fellowship in Hematopathology at BIDMC in July. She has a particular interest in High-grade B-Cell lymphomas and the genetic alterations of these lymphomas.